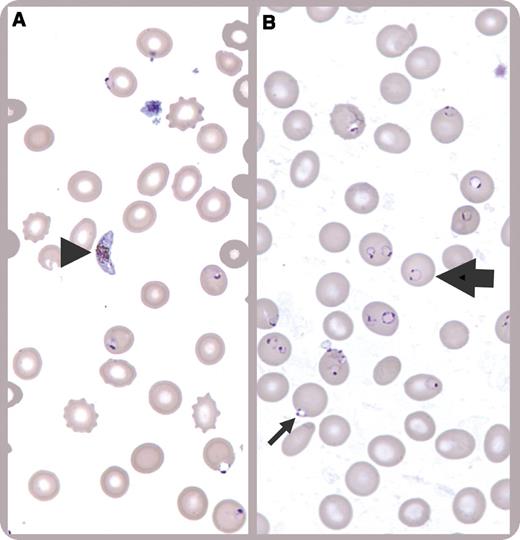
A 17-year-old teenager presented with fever and jaundice for 1 week that was preceded by 3 weeks of abdominal pain and malaise. The patient was born in The Gambia but had lived in the United States for most of his life except for the last 2 years, when he had returned to The Gambia. He was in the United States for 10 days at time of admission. Physical examination revealed depressed sensorium with a Glasgow Coma Scale of 15. He was afebrile and hemodynamically stable on admission but developed hypotension refractory to intravenous fluids, leading to transfer to the intensive care unit within 12 hours of presentation. A complete blood count showed a hemoglobin level of 6.1 g/dL with a nadir of 5.8 g/dL. The peripheral blood smear was diagnostic for Plasmodium falciparum, showing numerous intracellular parasites, with a calculated 28% parasitemia. There were crescent-shaped gametocytes (panel A, arrowhead), ring forms with split chromatin giving the typical “headphone” appearance (panel B, thick arrow), erythrocytes infected with multiple parasites, and appliqué forms (rings appearing on the periphery of the erythrocyte) (panel B, thin arrow). / He recovered after a transfusion of 4 units of packed red blood cells and treatment with quinidine and doxycycline, both administered intravenously.

A 17-year-old teenager presented with fever and jaundice for 1 week that was preceded by 3 weeks of abdominal pain and malaise. The patient was born in The Gambia but had lived in the United States for most of his life except for the last 2 years, when he had returned to The Gambia. He was in the United States for 10 days at time of admission. Physical examination revealed depressed sensorium with a Glasgow Coma Scale of 15. He was afebrile and hemodynamically stable on admission but developed hypotension refractory to intravenous fluids, leading to transfer to the intensive care unit within 12 hours of presentation. A complete blood count showed a hemoglobin level of 6.1 g/dL with a nadir of 5.8 g/dL. The peripheral blood smear was diagnostic for Plasmodium falciparum, showing numerous intracellular parasites, with a calculated 28% parasitemia. There were crescent-shaped gametocytes (panel A, arrowhead), ring forms with split chromatin giving the typical “headphone” appearance (panel B, thick arrow), erythrocytes infected with multiple parasites, and appliqué forms (rings appearing on the periphery of the erythrocyte) (panel B, thin arrow).
He recovered after a transfusion of 4 units of packed red blood cells and treatment with quinidine and doxycycline, both administered intravenously.
A 17-year-old teenager presented with fever and jaundice for 1 week that was preceded by 3 weeks of abdominal pain and malaise. The patient was born in The Gambia but had lived in the United States for most of his life except for the last 2 years, when he had returned to The Gambia. He was in the United States for 10 days at time of admission. Physical examination revealed depressed sensorium with a Glasgow Coma Scale of 15. He was afebrile and hemodynamically stable on admission but developed hypotension refractory to intravenous fluids, leading to transfer to the intensive care unit within 12 hours of presentation. A complete blood count showed a hemoglobin level of 6.1 g/dL with a nadir of 5.8 g/dL. The peripheral blood smear was diagnostic for Plasmodium falciparum, showing numerous intracellular parasites, with a calculated 28% parasitemia. There were crescent-shaped gametocytes (panel A, arrowhead), ring forms with split chromatin giving the typical “headphone” appearance (panel B, thick arrow), erythrocytes infected with multiple parasites, and appliqué forms (rings appearing on the periphery of the erythrocyte) (panel B, thin arrow).
He recovered after a transfusion of 4 units of packed red blood cells and treatment with quinidine and doxycycline, both administered intravenously.
For additional images, visit the ASH IMAGE BANK, a reference and teaching tool that is continually updated with new atlas and case study images. For more information visit http://imagebank.hematology.org.

This feature is available to Subscribers Only
Sign In or Create an Account Close Modal